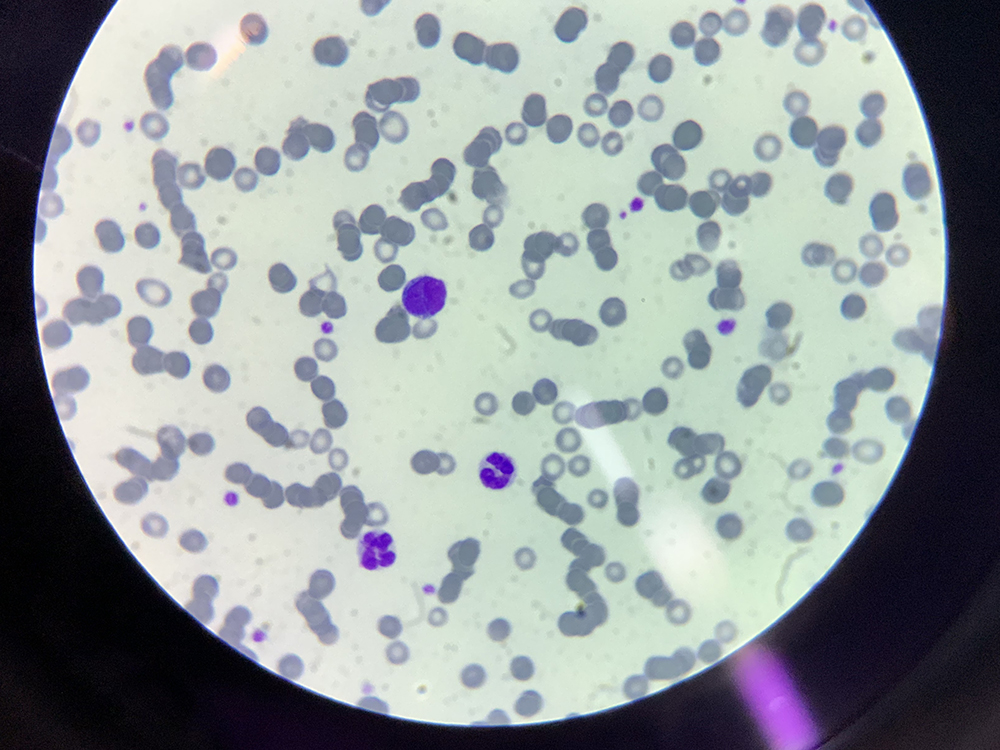
消化器型リンパ腫

皆さんの愛犬・愛猫でこんなトラブルありませんか?
- 下痢をしている
- 血便が出ている
- 吐いている
- 食欲が落ちた
- お腹が膨れてきた
- 元気がない
- 体重が減ってきた
愛犬・愛猫にこのような症状がある方は注意が必要です。
愛犬・愛猫の消化器の不調は飼い主様にとって大きな悩みの一つではないでしょうか。
消化器系の問題は、消化不良などからくる一時的な不調も多いですが、中には命に関わる深刻な病気が隠れていることもあります。
「下痢や嘔吐があったけど、元気はあるから大丈夫だと思っていた」
「もっと早く受診すればよかった」
愛犬・愛猫に深刻な問題が見つかった場合は、このように思われる飼い主様が多いです。
消化器系の病気は早期発見・早期治療が大切です。
少しでも気になる症状があれば、お気軽にご相談ください。

藤沢市にあるサーカス動物病院の検査・診断方法
当院では最新の医療機器を用いた精密な検査と診断を行っています。
- 血液検査
- 便検査
- レントゲン検査
- 超音波検査
- 内視鏡検査
上記の検査を症状に応じて実施しています。
体への負担が少ない検査から、詳細な情報が得られる検査まで幅広く対応可能です。
また、当院では飼い主様とのコミュニケーションを大切にしています。
愛犬の状態を詳しく伺った上で、適切な検査や治療をご提案いたします。

藤沢市にあるサーカス動物病院の特徴
動物に優しい診察空間
当院では、動物が安心して診察を受けられるよう、快適な診察空間を提供しています。動物がリラックスできるように配慮した空間設計により、診療に伴うストレスを最小限に抑えることが可能です。
動物たちの様子を見ながら不安を最小限に抑えられるように診察や治療を進めていきます。
飼い主様への丁寧な説明と指導
当院では、診断結果や治療方針について、飼い主様にわかりやすく丁寧に説明します。消化器の病気の治療には、飼い主様の理解と協力が不可欠です。
それぞれの消化器疾患で最適な食事療法や薬の使用法など具体的なアドバイスを提供いたします。
飼い主様との信頼関係を大切にし、愛犬・愛猫の健やかな暮らしを支えます。

安全性の高い麻酔処置
消化器疾患の処置は内視鏡や外科などの麻酔が必要になるケースが多いため、麻酔の安全性が重要となります。
当院では細やかな麻酔モニタリングにより麻酔中の体の変化に迅速に対応できるよう体制を整えています。
また、技術顧問として獣医麻酔専門医との連携があるほか、麻酔認定医も在籍しているため、麻酔のリスクの高い症例に対しても対応が可能です。実際にシニアと言われる年齢の子の処置は日常的に実施しており、麻酔事故も開業から現在まで生じておりません。

代表的な消化器科の症状例
犬と猫の急性胃腸炎
犬と猫の急性胃腸炎は、突然の嘔吐や下痢を引き起こす病気です。
急性胃腸炎の原因には以下のようなものがあります。
- 細菌感染
- ウイルス感染
- 寄生虫感染
- 食事の変更
- ストレス
軽度の急性胃腸炎は通常1〜3日程度で自然に治りますが、重症の場合は治療が必要です。
子犬では重篤化しやすいので注意しましょう。
嘔吐や下痢が続くと脱水症状が起こる可能性があります。症状が見られたら早めに動物病院を受診することが大切ですね。
症状が改善しない場合は重篤な疾患が隠れていることもあるので、更なる検査や治療が必要です。
当院では、丁寧な問診を行い、症状をよく観察することで適切な検査や治療をご提案しております。

犬の膵炎
犬の膵炎は、膵臓の炎症によって引き起こされる病気です。膵炎は膵臓から分泌される消化酵素が誤って活性化され、自身の組織を消化してしまうことで発症します。
特に急性膵炎は突然発症し、激しい症状を伴うことが多く、早急な治療が求められます。
慢性膵炎は症状が軽度であることが多く、長期間にわたって進行するため、見逃されやすいのが特徴です。
膵炎の診断には血液検査や超音波検査などが重要な役割を果たします。
当院では膵炎を疑う症状を認めた場合は、これらの検査を実施し、膵臓や周囲の臓器の状態を詳しく評価します。
膵炎は重症化すると全身に影響を与え、ショック症状を起こす怖い病気です。
早期の診断と適切な治療が愛犬の命を守ることにつながります。

犬の慢性腸症
犬の慢性腸症は3週間以上続く消化器症状を特徴とする病気で、下痢や嘔吐、体重減少などが見られます。
慢性腸症は軽症の場合にはほとんど症状が見られないこともあります。飼い主様が気づかないうちに病状が進行することがあるので注意しましょう。
慢性腸症を診断するには感染症や腫瘍などとの見極めが重要です。
慢性腸症の診断では、
- 血液検査
- 糞便検査
- 超音波検査
- 内視鏡検査
などを行い、総合的な評価を行います。
内視鏡検査は消化管の生検を行い、組織を採取することで腸粘膜の炎症や腫瘍細胞の有無を確認することが可能です。
当院では内視鏡検査をすることで正確に病態を把握し、食事療法や免疫抑制剤などの薬物療法といった治療の選択を行います。
慢性腸症は長期的な治療が必要になることも多く、当院では定期的なフォローアップも大切にしています。

犬と猫の消化器型リンパ腫
消化器型リンパ腫は消化管に発生する悪性腫瘍です。高齢の犬に多く見られ、慢性的な消化器症状や体重減少を引き起こします。
超音波検査や内視鏡検査を組み合わせ、細胞や組織を採取することで消化器型リンパ腫の診断が可能です。
抗がん剤治療は、消化器型リンパ腫において一般的な治療法であり、多剤併用化学療法が主流です。
この治療法では複数の抗がん剤を組み合わせることで腫瘍細胞に対する効果を最大化します。しかし、化学療法には副作用が伴うため、治療中は注意深い観察が必要です。
また腫瘍が限局的で切除可能な場合には外科手術が選択されることもあります。
消化器型リンパ腫は完治が難しいため、寛解を目指す治療が中心となります。寛解とは、腫瘍の症状が軽減し、通常の生活が可能な状態を指しますね。当院では、飼い主様と獣医師が密に連携し、最適な治療法を選択していきます。

藤沢菖蒲沢院Web予約
藤沢菖蒲沢院Web予約 横浜ゆめが丘院Web予約
横浜ゆめが丘院Web予約